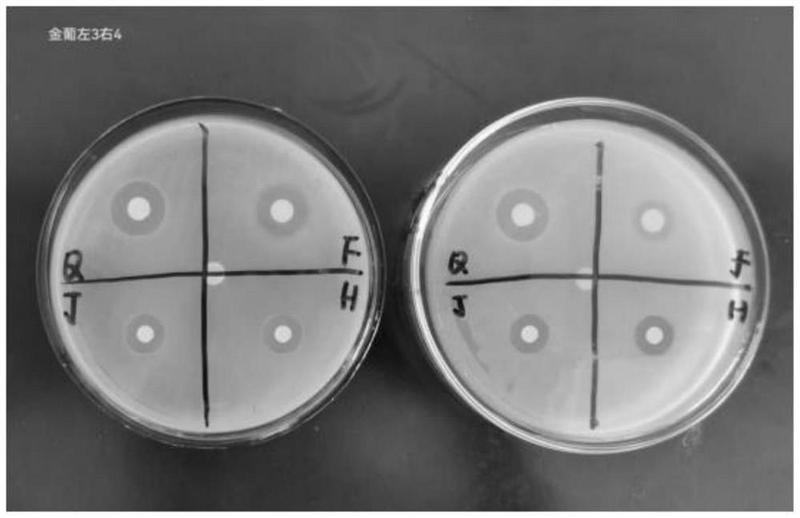
优选 苦参黄柏妇用抑菌

优选 苦参黄柏妇用抑菌
5g*5支
优选 苦参黄柏妇用抑菌
5g*5支
市场价
¥
36.0
峰伟价
¥
2.96
咨询客服,获取最新价格
有效期:2025-08-01
生产日期:2023-08-02
单位:盒
中包装:1
包装:200
是否拆零:是
- 规格
-
10mg*10s 40mg*10支 30mg*28s 25g 0.25g*12s*2板 0.31g*12s*2板 0.45g*12s*2板 30mg*2s 24s*50板 1g:0.1g*10袋 24s 50mg*24袋 20mg*20s 2ml:0.1g*10支 10ml*12支 0.5g 10袋 50mg*18袋 260ml 100ml:20g:0.9g 5ml:100mg 1ml:10mg*10支 10ml:1g*5支 0.5mg*100s 10ml*10支 80mg 3ml:150mg 0.1g*6袋 200mg 5ml:15mg 0.5g*10瓶 0.5g*20s 0.1g*7s 0.5g*12s*2板 10ml*8支 0.25g*12s*2板 5ml:175mg 80mg 2ml:15mg*10支 10ml*6支 0.3g*16s 2ml:0.5mg*6支/盒 15s*3板 15g*20袋 4000AxaIU 20mg*30s 5ml:0.125g*5支 100mg 20mg*2s 100s 0.125g*12包 0.3g*12s*2板 5g*5支 0.314g*36s 0.1g*20s 200ml:0.4g 40mg*14s 80mg:5mg*7s 0.5g*10s*2板 2ml:15mg*10支 0.125g*14袋 6s*2板 2ml:0.1g*10支 200ml 0.23g*10s*4板 3g*12袋 6g*8袋 4ml:40mg 10mg*50s 6g*20袋 10ml*10支 50s*10袋 10mg*8s 0.5g*24s 0.5g*60s 24s 20ml:0.4g*10支 2.5g*9袋 0.1g*6袋 10ml:2.5g*5支 0.5g*10支 4ml:0.4g*5支 10mg*24s 5g*9袋 2ml:15mg 200ml:2g 10ml*12支 11g*6袋 10ml*10支(5ml:15mg) 0.5mg*60s 12s*2板 2.4g(400万单位) 20ml 100mg 400mg 0.1g*10s*2板 0.55g*8s*2板 10ml:35mg 50mg*10s*2板 20ml:0.4g*10支 3g*14袋 5mg*14s 0.2g*10瓶 2mg*12s 5g*10袋 10g*10袋 10mg*10袋 18g*10袋 0.9g 0.36g 2ml:0.6g*10支 12s 5mg*12s 5mg*7s*2板 0.2g*10支 1ml:10mg*10支 100s 统 12s*4板 3g*3支 100mg 5ml*10 4ml:40mg*5支 20ml:4g*5支 10mg*100s 1.5ml(3ml:0.3g) 0.5g*30s 10ml*10支 1g*9袋 1%(20g:0.2g) 9g*8丸 12s*2板 0.26g*12s*2板 0.5g*10s*3板 160万(0.96g) 0.35g*12s*2板 40ml*2瓶 10g*6袋 2ml*0.5mg*5支 0.5g*10s*2板 25mg*100s 2g 10g*15% 20s 100mg*12s 8mg*16s 0.25g*6s 100mg 5mg*12s 2ml:0.5g*10支 5mg*60粒 0.5g 0.1g 2ml:4mg*10支 125g 6g*10袋 0.25g*13袋 0.4g*10s*2板 15ml*6支 0.1g*100s 10g*10袋 18s*5板*4小盒 15mg*14s 0.125g 1.2g*10支 2ml*10支 25mg*100s 75mg*12s 0.1g*6袋 50mg*8s 10ml:0.3g*5支 0.4g*16s 10ml*13支 1ml:25mg*2支 2ml:250ug*10支 1.5mg*20s 28s 9g*9袋 16袋 9g*8丸 1g*10袋 0.25g*12s*2板 5mg*20s*3板 2ml*10支 50mg*12s*2板 160mg 15s*4板 7g*10袋 10g*20袋 2.25g 0.4ml:4000AXaIU*2支 1ml:20mg*10支 5mg*14s 0.125g*16s 0.25g*10瓶 20ml:4g*5支 3g*10丸*3板 5g*9袋 5ml:5mg*4支 2ml:0.4g 10ml*10支 40mg*10支 100mg 30g 40mg 1ml:25mg*2支 5mg*6s 2ml 30mg*1s 7g*9袋 0.25ug*10s 60mg*100s 0.5g 10g*6袋 2ml:4mg*10支 12g*10袋 0.1g*100s 3g 10g*6袋 12s*2板 200mg 2ml:250ug*10支 6g*12袋 300mg*9s 0.1g*100s 2ml:2mg*5支 0.36g*12s*2板 2ml:100mg*10支 10ml:30mg*5支 0.5g*7s*3板 100mg 10mg*60s 5mg*100s 46ml 150ml 5ml 0.2g*12s*2板 2ml:0.25g*10支 20g 25mg*7s*2板 2ml:0.25g*10支 5ml*50支 2ml:0.25g*10支 150g 45s 0.1g*12s*2板 6g*12袋 20ml:10g*5支 0.4g*12s*3板 100ml:0.5g:0.9g 2.5ml:5mg*10瓶 0.1g*12s*2板 50mg*10s*2板 10ml*10支 75mg*10s 1g*18袋 50mg*14s 0.4g*10s*4板 10mg*100s 50mg*18袋 12s*2板 5g*9袋 20mg*12s 100ml 0.125g 0.3g*15s*3板 2g 0.35g*24s 0.125g*50s*400 24s 10g:1g 0.1%:30ml 0.3g*48s 0.25g*12s*2板 10mg*48s 0.125g*15袋 0.1g*8s 10s*2板 统 1g 0.5g*24s 0.5g*12s*2袋 2ml:100mg*10支 18s 5g*10袋 0.125g 0.1g*20s 1.0g 2ml:20mg*10支 0.5g*12s 2ml:15mg*10支 1ml:10mg*10支 20s*2板 50mg*100s 1g 0.1g*10s*2板 20袋 10ml*10支 100单位 5%(60g:3.0g) 10g*6袋 0.425g*13s*2板 10g*7袋 2ml:0.1g*10支 5ml:5mg 7g 40mg 0.75g 50ml*2瓶 14g*9袋 2ml:4mg*10支 100mg 12s 100ml:4g:0.9g 1g 0.1g*12s 10ml*6支 0.1g*12s 10mg*100s 80ml(0.0005%) 0.25g*12s*2板*3小盒 15g*6袋 5.6g*10s 12s*2板 20mg*24s 2ml:0.1g*10支 5ml:1.25mg 10ml 2.5mg*14s*2板 30mg*3s 12.5cm*12.5cm 0.3g*7s*2板 0.5g*10支 0.5g*12s 0.5g*30s 20袋 0.35g*24s 2ml:0.5g*10支 0.25g 10mg*10s*2板 40mg*7s*2板 4mg*100s 0.2g*10s 12袋 0.1g*1瓶 0.5g*12s*3板 0.36g*24s*3板 2ml:4mg*10支 0.4g*12s*2板 15mg*12s 5mg*30s 10ml*5支 0.25g*12s*4板 2g 20mg*20s 10ml*6支 2ml:20mg*10支 5ml:0.1g*5支 2ml:8mg 40ml*2瓶 0.5%(5ml:25mg)*1支 7cm*10cm*3片*2袋 0.25g*30s 0.5g*30s 0.5g*10瓶 10mg*48s 0.1g*9袋 2g*10袋 50mg*2s 3.5g*11丸*1板 0.25g*24s*2板 统 2ml*10支 0.1g*12s*4板 100mg 120ml 10ml*10支 10ml:0.25g*5支 2ml:4mg*10支 0.67g*15袋 1.5ml:0.375g 10mg*7s 10g:2mg 40mg*16s 0.1g*6s 100mg 1%*60ml 0.2g*15s*2板 10ml*6瓶 12s*2板 6g*10袋 8g*6袋 24s 0.25g*10s*2板 20ml:5g*5支 5g*10袋 2ml*10支 1g:0.1g*10袋 0.1g*6袋 19袋 40mg*14s 10mg*12袋 0.5g 100mg 10mg*12s*2板 20ml:5g*5支 5ml 5g*6袋 4mg 10s*4板 10ml*6支 12s*3板 5g*10袋 0.35g*12s*6板 统 0.5g*10瓶 0.4mg*31s*2板 选 100s 5g*9袋 12包 80mg*10瓶 100mg 60mg*12s 380ml 12g*9袋 100s 50mg*5支 30mg*100s 2.5mg*14s*3板 75mg*12袋 2g 100mg 2ml:0.5g*10支 10mg*10s 0.5g*24s 0.4mg*31s*3板 0.3g*10s*12板 0.15g*10s*2板 5ml:24.4mg 2.5g*12袋 0.125g 27片*30袋*30盆 2ml:60mg*10支 400mg 0.5g*48s 0.2g*10s 0.25mg*30s/板 9g*10袋 2ml:0.25g*10支 3g*8袋 2ml:20mg*10支 2ml:60mg*10支 0.125g*12袋 100s 2.5ml:5mg 统 12g*6袋 10g*6袋 30丸*12袋 200ml:2g 0.25g*100s 15s*3板 100mg*120s 1ml:10mg*10支 100mg 20g*12袋 1ml:1mg*10支 120ml 5ml:37.5mg*5支 0.5g*5瓶 选 400mg 10g*10袋 2ml:15mg 0.3125g*10s 118s 1.5mg*30s 0.35g*12s*4板 0.25g*10支 48s*2板 60mg*15s*2板 24s 80mg 100ml:2g 10ml:0.1g*6支 20ml:30mg*4支 5g*10袋 12g*10袋 0.5g*5s*2板 0.2g*10瓶 0.1g*7袋 5ml*10支 2ml*10支 10s 0.5g*5s*2板 12s*4板 0.87g*27s 10ml*2支 1.5g*80s 50mg*36s 0.125g*10袋 0.4g*12s*4板 1ml:0.5mg*5支 0.4g*12s*2板 1ml:2mg*10支 1.5mg*250丸 50mg*6袋 10g*10袋 0.125g 0.4g*12s*6板 480丸 10ml:90mg*5支 12袋 3g*8袋 统 12s 0.1g*100s 0.5g*10s*2板 0.33g*36s 0.1g*9s*1板 20mg*30s 20ml:0.4g*10支 9g*6袋 3ml:150mg 2ml:0.2g*10支 0.25g*12s*2板 5ml:0.1g*5支 1g*24s 1ml:10mg*10支 12s*2板 10ml*10支 2g*12袋 100ml:5mg:0.9g 8ml:8mg 10g*10袋 10ml:0.1g*6支 100ml:20g:0.9g 0.15g*12s*2板 0.2g*12s 80mg*10瓶 250ml 4mg*10瓶 0.125g*7袋 0.5g*10包 10ml*11支 100mg 60s 100mg*16s 12s 0.25g*18s*4板 100mg 0.4g*10s*2板 0.25g*18s*4板 10ml*6支 2ml:15mg 45s 0.45g*12s*3板 10ml*10支 8ml:8mg 20s 0.3g*12s*2板 18g*10袋 0.8mg 10ml*10支 0.2g*10s*2板 10ml:35mg*12支 20ml:4g*5支 3ml:150mg 0.25g*6s 5mg*12s 80mg 100ml 0.25g*24s 2g 10ml*6瓶 50mg*100s 10ml:0.1g*6支 2ml:0.2g 0.35g*12s*2板 2ml:20mg*10支 1g:0.1g*10袋 10ml*9支 0.25g 10g 1ml:2mg*10支 33mg*120丸 0.25ug*10s*2板 10ml*10支 1g*24s 25mg*100s 100mg 10s 60mg*12s 1ml:50mg*10支 100mg 10ml*2支 0.45g*6s*3板 7*10cm*10片 20ml;0.2g*2支 10mg*14s 2ml:60mg*10支 0.35g*12s*2板 2ml:60mg*10支 10ml*12支 1kg 10g*10丸 40s*4板 1ml:5mg*10支 1ml*10mg*5支 25mg*12s*3板 2ml:0.5g*10支 0.36g*2瓶 0.125g 10ml:0.1g*5支 14s*3板 5mg*20s 5mg*10s*2板 0.1g 8ml:8mg*2支 0.1g*100s 8mg*18s 1ml:0.1mg*10支 3ml:3mg 24s*1袋 16s*3板 0.5g 0.1g*15袋 0.5g*10s 30s 0.1g*20s 50mg*8s*2板 10g*9袋 50mg 15s*10板 2ml:100mg*10支 1ml:0.3mg*2支 11袋 1ml:10mg*2支 5g*52袋 7cm*10cm*6贴*1袋 3g*10袋 80mg*10瓶 1g 60mg*100s 100ml:0.3g:5g 0.125g*10瓶 0.25g*1000s 50ml:10g:0.45g 5ml:20mg 15g*2瓶 120ml 16袋 10ml*9支 24S 2.5mg*10s 0.3g*18s*2板 5ml:20mg 2ml:0.5mg*6支 10ml*10支(5ml:15mg) 6g*9袋 0.5mg*100s 0.15g*5s*2板 0.32g*18s*5板 100ml:50g 30s 25ml*4瓶/90 0.25g*24s 0.2g*10瓶 35mg*10s*3板 5mg*30s 0.45g*24s 10ml:100mg*10支 0.26g*24s 1ml:0.1g*10支 2ml:60mg*10支 10mg*6袋 0.5g*20s 0.25g*50s 2ml:10支 0.5g*100s 10ml*10支 400单位*12s*3板 5g*18袋 12s*5板 20mg*1s*3板 6g*10袋 10ml*10支 10ml*7支 0.35g*12s*2板 1.5mg*30s 160万(0.96g) 24s*2板 0.25g*6s 0.36g 0.5g 10ml*10支 0.5g*10s*2板 100ml:2g 50mg*6s 10ml:0.25g*5支 100ml:0.5g:0.825g 0.25g*6袋 2ml:20mg*10支 10s 2ml:0.4mg*2支 10mg*7s 4ml:40mg*5支 7g*9袋 5ml:0.125g*5支 80mg*10瓶 0.5mg*60s 0.1g*100s 1g*9袋 0.25g*10支 24s 2ml 0.75g 5g*10袋 2ml:4mg*10支 250g 10袋 5ml:175mg 4mg*100s 20mg*7s 40mg*24s 10s*1板 0.4g*12s*2板 100s 200ml 24s*50板 30s 10ml:2.5g*5支 1ml:0.5mg*5支 10g*5袋 60ml*2% 50ml 10g*3瓶 100ml:2g 8mg*100s 10ml*17支 0.1g*7s 36s 10ml*12支 选 1ml:25mg:10支 0.5g 1g*18袋 10g*3瓶 0.35g*12s*2板 1.125g 6g*10袋 0.25g*12s 160mg 100mg 2ml:100mg*10支 0.1g*6袋 9粒 0.5g 0.1g*12s 统 1ml:5mg*10支 2ml:60mg*10支 18g*8袋 4g*6s 统 10ml:0.25g*5支 80mg 0.1g*6袋 5ml:1g 200s 100s 0.25ug*10s 10g*9袋 5mg*100s 18g*8袋 2.5ml:5mg 20mg*14s*5板 6g*10袋 6g*10袋 0.1g*12s*2板 0.25g*48s 0.4g*24s 50mg*6袋 5g*10袋 2ml*10支 100mg*6袋 2ml:100mg 3g*20袋 12s 5mg*8s 2ml:0.1g*10支 0.3g*100s 0.4g*10s*3板 20mg*12s*4板 60ml*2% 2ml:0.1g:40mg:18mg*10支 60mg*100s 100mg*6袋 1ml:100mg*10支 100ml 10mg*5支 10mg*10s*2板 0.5g*100s 1.5mg*30s 20ml:30mg 6枚 2ml 27s*10袋/瓶 2g 10s 20mg*100s 1ml:5mg*10支 0.5g*10s*2板 100mg 10ml:2.5g*5支 8ml:8mg 75mg*10袋 10ml 9g*9袋 2.5g*5袋 0.1g*100s 10ml*10支 片 2ml*10支 20mg*14s 0.2g 100mg 2ml:4mg*10支 2ml:60mg*10支 2ml:60mg*10支 120mm*50mm*1贴*4袋 14s*3板 50mg*2s 9g*10丸 10ml*10支 12s 10g*11袋 20mg*7s 5ml:0.125g*5支 0.3g*12s*4板 0.35g*16s*2板 0.25g*12s*6板 100mg*6袋 100mg 0.64g*18s 0.5g*10s*2板 5mg*25s*2板 5mg*24s 4ml:30mg*6支 20ml:30mg*4支 10ml*6支 10g*9袋 10g*12袋 1ml:0.3mg*2支 0.15g*12s 2ml:0.25g*10支 1ml:2mg*10支 0.5g*20s 5mg*16s 统 1.5mg*16袋 0.1g*100s 100s 2.25g 4ml:0.3g 0.5g*12s*3板 25mg*50s 3g*6瓶 20ml*5支 50ml 2g 2ml:60mg*10支 统 8g*6袋 0.5g*400s 2ml:0.1g*10支 3g*10丸 10ml*6瓶 1ml:0.3mg*2支 10ml:2.5g*5支 4ml:40mg 11g*6袋 250g 81mg*24s 10mg*6s*5板 0.25g*6袋 0.25g*6s 15mg*12s 36s 10mg 1ml:2mg*10支 10ml*5支 6g*10丸 10g*9袋 80mg 30mg*2s 2mg*12s 1.0g 0.25g*10瓶 0.35g*10s*3板 2ml:60mg*10支 100s 100ml:0.2g:0.9g 统 40mg*8s 0.5g 9袋 300mg*7s 16s 10ml:2.5g*5支 1.0g 1mg*30s 0.25g*12s*2板 0.1g*100s 10g*15% 0.25g*100s 2ml:8万单位*10支 10ml:20mg*10支 80mg 2ml:60mg*10支 20mg*24s 2ml:0.2g*10支 1.5g*10瓶 2ml:100mg*10支 2ml:5mg*8支 0.5g*10瓶 6g*10袋 0.125g*8袋 10g*10袋 10mg*100s 15mg*20s*40袋 3ml:3mg*5支 10ml:2.5g*5支 200mg 1ml:1mg 0.125g*12包 15s*3板 1.0g*10瓶 40mg*7s 1.25g*10瓶 5mg*10s*2板 1ml:1mg*10支 380ml 0.5g*20S 0.1g 15mg*12s 0.2g 统 24s*50板 0.5g*120s 50mg*100s 2ml:0.1g*10支 10ml*12支 20mg 5mg*12s*2板 10mg*10瓶 0.3g*18s*2板 1g 0.5g*60s
- 数量
优惠券
可领优惠券
输入回拨电话
苦参黄柏妇用抑菌说明书
请仔细阅读说明书,并在医生指导下使用
- 商品名称
- 苦参黄柏妇用抑菌
- 品牌
- 优选
- 含量规格
- 5g*5支
- 批准文号
- 国药准字H20237102
- 生产企业
- 江西乐尔康实业有限公司
- 通用名称
- 苦参黄柏妇用抑菌
- 有效期
- 2025-08-01
- 生产日期
- 2023-08-02
- 单位
- 盒
- 中包装
- 1
- 包装
- 200
- 是否拆零
- 是
用药指导
相关问答
如何辨别药品真伪
-
方法1:查国药准字号
所有正规药品都具有国药准字号,您可以登录国家药监局网站-数据查询页面-输入国药准字号,如果能查到就是真药,否则就是假药。
-
方法2:包装是否完整
购买药品的时候可以检查包装是否破损,有无拆封过的迹象,有无被破坏的情况,如果出现上述情况,请谨慎购买。
-
方法3:肉眼判断方法
真药的包装印刷一般文字图片都非常清晰容易辨别,部分药品有防伪码,假冒伪劣药品一般为降低成本印刷粗糙很容易辨别真伪!
-
方法4:扫描条形码辨别法
药品外包装都会有条形码,这是出厂必须具有的,可以通过智能手机的扫一扫功能查询,能查到药品信息的是真药,扫码结果为空的,要格外留意药品质量。
-
方法5:药品批号辨别法
药品出厂的时候,都会在外包装盒上标明,生产日期、有效期、药品批号等基本信息,如果外包装盒上没有批号,基本可以判断为假药。
-
方法6:药品电子监管码辨别法
药品电子监管码是药品的身份证,国内目前大约60%的药品都具有监管码,通过支付宝或者微信扫一扫,真药会显示药品的基本信息,假药就查不到。
-
方法7:购买渠道筛选法
药品一般建议去正规的医院、药店、诊所购买,这样买到假药的概率会很小,如果选择网上购买,购买前一定要看清网站是否有药店资质或具有互联网售药资格。
-
方法8:机构检验法
随着制假技术的提高,普通消费者不容易辨别真伪,可以选择把药品送到相关检测机构去检测药品成分,如果药品所含成份与国家药品标准规定的成份不符,既是假药。
-
方法9:拨打厂家电话验证真假
如果您通过以上提供的方法还是无法确定药品的真伪,可以选择去药店查看此药品包装盒上的厂家电话,然后拨打求证如何验证此药品的真假方法。